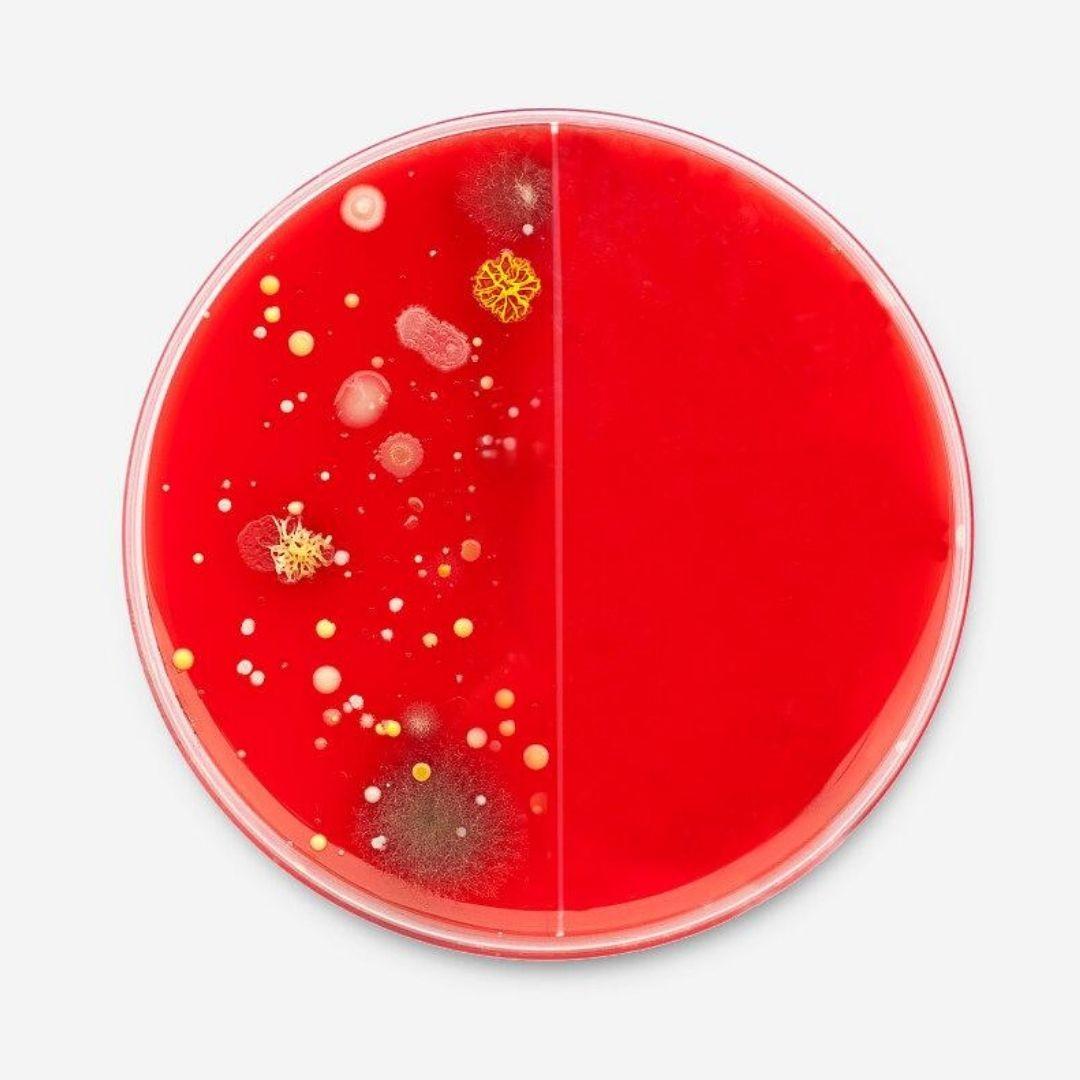

A E R I S ®
PERFECTE LUCHTZUIVERING
Alle luchtzuiveraars van aeris zijn streng getest volgens de hoogste normen van derden, waaronder de AHAM AC-1-test, coronavirustests en nog veel meer.
SHOP NU!
BACTERIËN & VIRUSSEN
Luchtwegaandoening of ziektes bij uw kinderen, dit toestel met zijn bacteriën en micro-organismenfilter kan u de gemoedsrust geven waar u naar op zoek bent.

SCHIMMEL
Maak je nooit meer zorgen over schimmel! Schimmel is een van de lastigste stoffen in de lucht om mee om te gaan. Maar onze luchtzuiveraars zijn gemaakt voor uw behoeften.

ALLERGIËN
Perfect voor iedereen die aan allergieën lijdt. Stof, pollen, huidschilfers of andere allergieën. Vuile neus? Rode ogen? Niezen en hoesten? Aeris is er voor u.

GEUREN
Geuren zijn een constant gedoe voor elk huis. Met dit in het achterhoofd hebben we een luchtzuiveraar ontworpen om zelfs de sterkste geuren, zoals verf en spuitbussen, volledig te elimineren.

ASTMA
Maak uw huis veilig voor astmapatiënten. Of u nu zelf last heeft van astma of u probeert een veilig thuis voor iemand in uw familie te garanderen, De aeris luchtreiniger is speciaal voor u gemaakt.

ZWARE VERVUILING
Wanneer verontreinigende stoffen gevaarlijk worden, is luchtzuivering absoluut noodzakelijk. De Aeris is ontwikkeld om dit probleem grondig aan te pakken, alle vervuilende stoffen worden verwijderd en geëlimineerd.

INTELLIGENT
Met behulp van IAQ-sensortechnologie leert de lucht in de loop van de tijd effectiever en efficiënter te werken. Dit betekent dat het zowel beter loopt en minder energie verbruikt hoe langer je het bezit.

VOOR KAMERS VAN 68 M² EN GROTER
De lucht is gemaakt voor grote slaapkamers, woonkamers en kantoren. Dus wat je ook nodig hebt, deze krachtige machine zal het voor elkaar krijgen.

FLUISTERSTIL
De lucht werkt met 35dB(a) in de nachtstand, wat vergelijkbaar is met het geluid van een stil gefluister. U slaapt dus de hele nacht comfortabel en diep.
DETAILS
Kamergrootte: Tot 68 m²
CADR:11,8 m³ /min.
Ventilator: EBM papst
Vermogen: 25W | >50W (max)
Geluid: 35 - 65 dB
WiFi-connectiviteit: IEEE 802.11b/g/n
PM2.5/PM10 Sensor: aeris asense
Filterklasse: F7 en H13
Gasfilter: Actieve kool en actief aluminiumoxide
Filterlagen: 3
Afmetingen: 36,98× 38,68 ×59,99cm
Gewicht: 15 tot 18kg
SHOP NU!EN ALLES-IN-ÉÉN-OPLOSSING
SOMS IS EEN KLEINE LUCHTREINIGER NIET GENOEG: VOOR GROTE KLUSSEN HEB JE EEN GROTE LUCHTREINIGER NODIG. DAT IS WAAR DE AAIR 3-IN-1 PRO OM DE HOEK KOMT KIJKEN: HIJ IS GEMAAKT VOOR KAMERS VAN 68M² EN GROTER, EN GEBOUWD OM MEERDERE PROBLEMEN, WAARONDER HET CORONAVIRUS, IN ÉÉN KEER AAN TE PAKKEN.
MET BEHULP VAN DE NIEUWSTE TECHNOLOGIE EN SLIMME LEERSOFTWARE KAN DE AAIR MEER DAN 99,7% VAN DE VERVUILENDE STOFFEN IN DE BINNENLUCHT ELIMINEREN, TERWIJL HIJ IN DE LOOP VAN DE TIJD EFFICIËNTER EN EFFECTIEVER WORDT


Coronavirus uit de lucht halen
Met behulp van de meest geaccepteerde tests op de markt om de effectiviteit van de luchtzuivering te meten, is aangetoond dat luchtzuiveringsapparaten van aeris 94% van de Feline Coronavirus uit de lucht in een ruimte verwijderen en 99,95% van bacteriën en nog veel meer vervuilende stoffen in de lucht.
Anti-bacteriële coating
Aeris integreert anti-microbiële technologie in zijn luchtfilters die werkt door de celmembraan van de microben te verstoren en hun vermogen tot replicatie uit te schakelen.
Alle oppervlakken van aairlite en zijn filters, evenals op aair medical Pro modellen zijn met deze technologie behandeld.
Deze technologie betekent dat deze aeris luchtreinigers ideaal zijn voor zelfs de meest gevoelige mensen, zoals kinderen, ouderen en mensen met gevoelige longen.

Luchtzuivering sneller en beter (CADR)
CADR staat voor Clean Air Delivery Rate. Eenvoudig gezegd meet het hoe snel de lucht in een bepaalde ruimte wordt gefilterd. Een luchtreiniger met een CADR-classificatie van 300 cfm reinigt een ruimte van 300 m² veel sneller dan een luchtreiniger met een CADR-classificatie van slechts 200 cfm.
Aeris luchtreinigers hebben hun CADR geoptimaliseerd om hoog genoeg te zijn om uw ramen en deuren open te houden, en ze zouden net zo effectief zijn. Dat is drie keer zo snel als vergelijkbare luchtreinigers, waardoor onze luchtreiniger tot de snelste en meest efficiënte luchtreinigers behoort.

HEPA opnieuw uitgevonden: De Nul-telling
HEPA staat voor 'high-efficiency particulate air' en wordt beschouwd als de gouden standaard voor het meten van de effectiviteit van luchtzuivering.
HEPA meet de verschillende grootte van de deeltjes die door een filter komen, van grote deeltjes zoals dieren haren tot ongelooflijk kleine deeltjes zoals virussen. Onze luchtzuiveraars zijn geperfectioneerd tot het punt waarop elk resultaat als nul uitkomt. Met andere woorden, onze filters bereiken de maximaal mogelijke HEPA-waarde.

Geen Ozone meer
Volgens de EPA: "Bij inademing kan ozon de longen beschadigen. Relatief lage hoeveelheden kunnen pijn op de borst, hoesten, kortademigheid en keelirritatie veroorzaken. Ozon kan ook chronische luchtwegaandoeningen zoals astma verergeren en het vermogen van het lichaam om luchtweginfecties te bestrijden in gevaar brengen".
M.a.w. , de ozon die door sommige luchtzuiveraars wordt gegenereerd, doet het tegenovergestelde van ons beschermen tegen vervuiling: het verschuift gewoon het gevaar van het ene gebied naar het andere.
Maar aeris zet zich in voor het effectief verwijderen van gevaarlijke vervuilende stoffen, terwijl er ook geen ozon vrijkomt. Onze gepatenteerde antimicrobiële coating stelt ons in staat om precies dat te doen: het verwijderen van het soort deeltjes dat de ozonlaag van de luchtreinigers verwijdert, maar zonder schadelijke neveneffecten.

